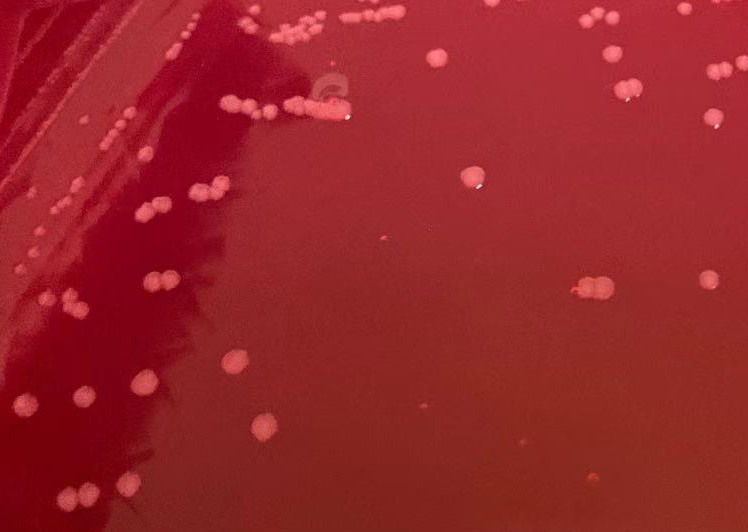
甲型副伤寒沙门菌CMCC50093 无色菌落,无黑心 甲型副伤寒沙门菌CMCC50093 无色菌落,无黑心

相关产品推荐更多 >
万千商家帮你免费找货
0 人在求购买到急需产品
- 详细信息
- 文献和实验
- 技术资料
- 库存:
999
- 英文名:
Xylose Lysine Desoxycholate(XLD)Agar
- 保质期:
三年
- 供应商:
青岛海博生物
- 规格:
250g
用途:用于沙门氏菌的选择性分离培养。
成分(g/L)
| 酵母浸粉 | 3.0 |
| L-赖氨酸 | 5.0 |
| 乳糖 | 7.5 |
| 蔗糖 | 7.5 |
| 木糖 | 3.75 |
| 氯化钠 | 5.0 |
| 硫代硫酸钠 | 6.8 |
| 柠檬酸铁铵 | 0.8 |
| 脱氧胆酸钠 | 2.5 |
| 苯酚红 | 0.08 |
| 琼脂 | 15.0 |
| pH值7.4 ± 0.2 | 25℃ |
检验原理:
酵母浸粉为细菌生长提供维生素和辅助因子,木糖、乳糖和蔗糖作为可发酵碳源。除志贺氏菌外,其他大多数肠杆菌均发酵木糖,加入赖氨酸是为了鉴别沙门氏菌。沙门氏菌发酵木糖产酸,形成的酸性环境有利于该菌产生脱羧酶,沙门氏菌使赖氨酸脱羧,从而使培养基的pH 升高向碱性转变,但这种转变可因其他菌发酵乳糖和蔗糖产生大量的酸而被阻止。
在碱性的条件下,硫代硫酸钠及柠檬酸铁铵与沙门氏菌产生的硫hua氢反应,使得菌落的颜色呈黑色;但当酸性条件下时,这种反应被抑制。苯酚红作为酸碱指示剂,氯化钠维持体系渗透压平衡,去氧胆酸盐抑制革兰氏阳性菌的生长。
用法:
称取本品57g,加热煮沸搅拌溶解于1000ml蒸馏水中,勿过度加热,勿高压灭菌。冷至48℃±2℃时,倾入无菌平皿,部分开盖,干燥后盖上,备用。
不同细菌在XLD培养基上的生长特征:
![]() |
![]() |
![]() |
||
|
肠炎沙门氏菌CMCC50760 无色菌落,有黑心 |
|
大肠埃希氏菌ATCC25922 黄色菌落 |
|
福氏志贺氏菌CMCC51572 无色菌落,无黑心 |
![]() |
![]() |
![]() |
||
|
甲型副伤han沙门菌CMCC50093 无色菌落,无黑心 |
|
奇异变xing杆菌CMCC49005 黄色菌落,有黑心 |
|
鼠伤寒sha门氏菌ATCC14028 无色菌落,有黑心 |


风险提示:丁香通仅作为第三方平台,为商家信息发布提供平台空间。用户咨询产品时请注意保护个人信息及财产安全,合理判断,谨慎选购商品,商家和用户对交易行为负责。对于医疗器械类产品,请先查证核实企业经营资质和医疗器械产品注册证情况。
文献和实验参考文献: 1. GB/T8538-2008 中华人民共和国国家标准 饮用天然矿泉水检验标准 (责任编辑:大汉昆仑王)
相关专题 琼脂 粉Agar 琼脂 粉质量标准符合国标GB1975-80规定:干燥失重:≤15%烧灼残渣%(灰分):≤5 水不溶物%:≤1 砷(AS)%:≤0.0001 重金属(以Pb计)%:≤0.004 吸水力:75毫升(最高数)淀粉:合乎规定凝胶强度:>800g/cm2 产品优点凝胶强度:>800g/cm2 琼脂 粉Agar组培上的应用说明:培养基的配制,别名:Agar-agar;Gum agar 分子式:(C12H18O9)n 工作
内,肠杆菌科常见属种的反应结果见表2。 表2 肠杆菌科各属在三糖铁琼脂内的反应结果 说明:在三糖铁琼脂内只有斜面产酸并同时硫化氢(H2S)阴性的菌株可以排除,其他的反应结果均有沙门氏菌的可能,同时也均有不是沙门氏菌的可能。 5.3.2 在接种三糖铁琼脂的同时,再接种蛋白陈水(供做靛基质试验)、尿素琼脂(pH7.2)、氰化钾(KCN)培养基和赖氨酸脱竣酶试验培养基及对照培养基各1管,于36±1℃培养18~24h,必要时可延长至48h,按表3判定结果。按反应序号分类,沙门氏菌属的结果应属于A1
技术资料暂无技术资料 索取技术资料